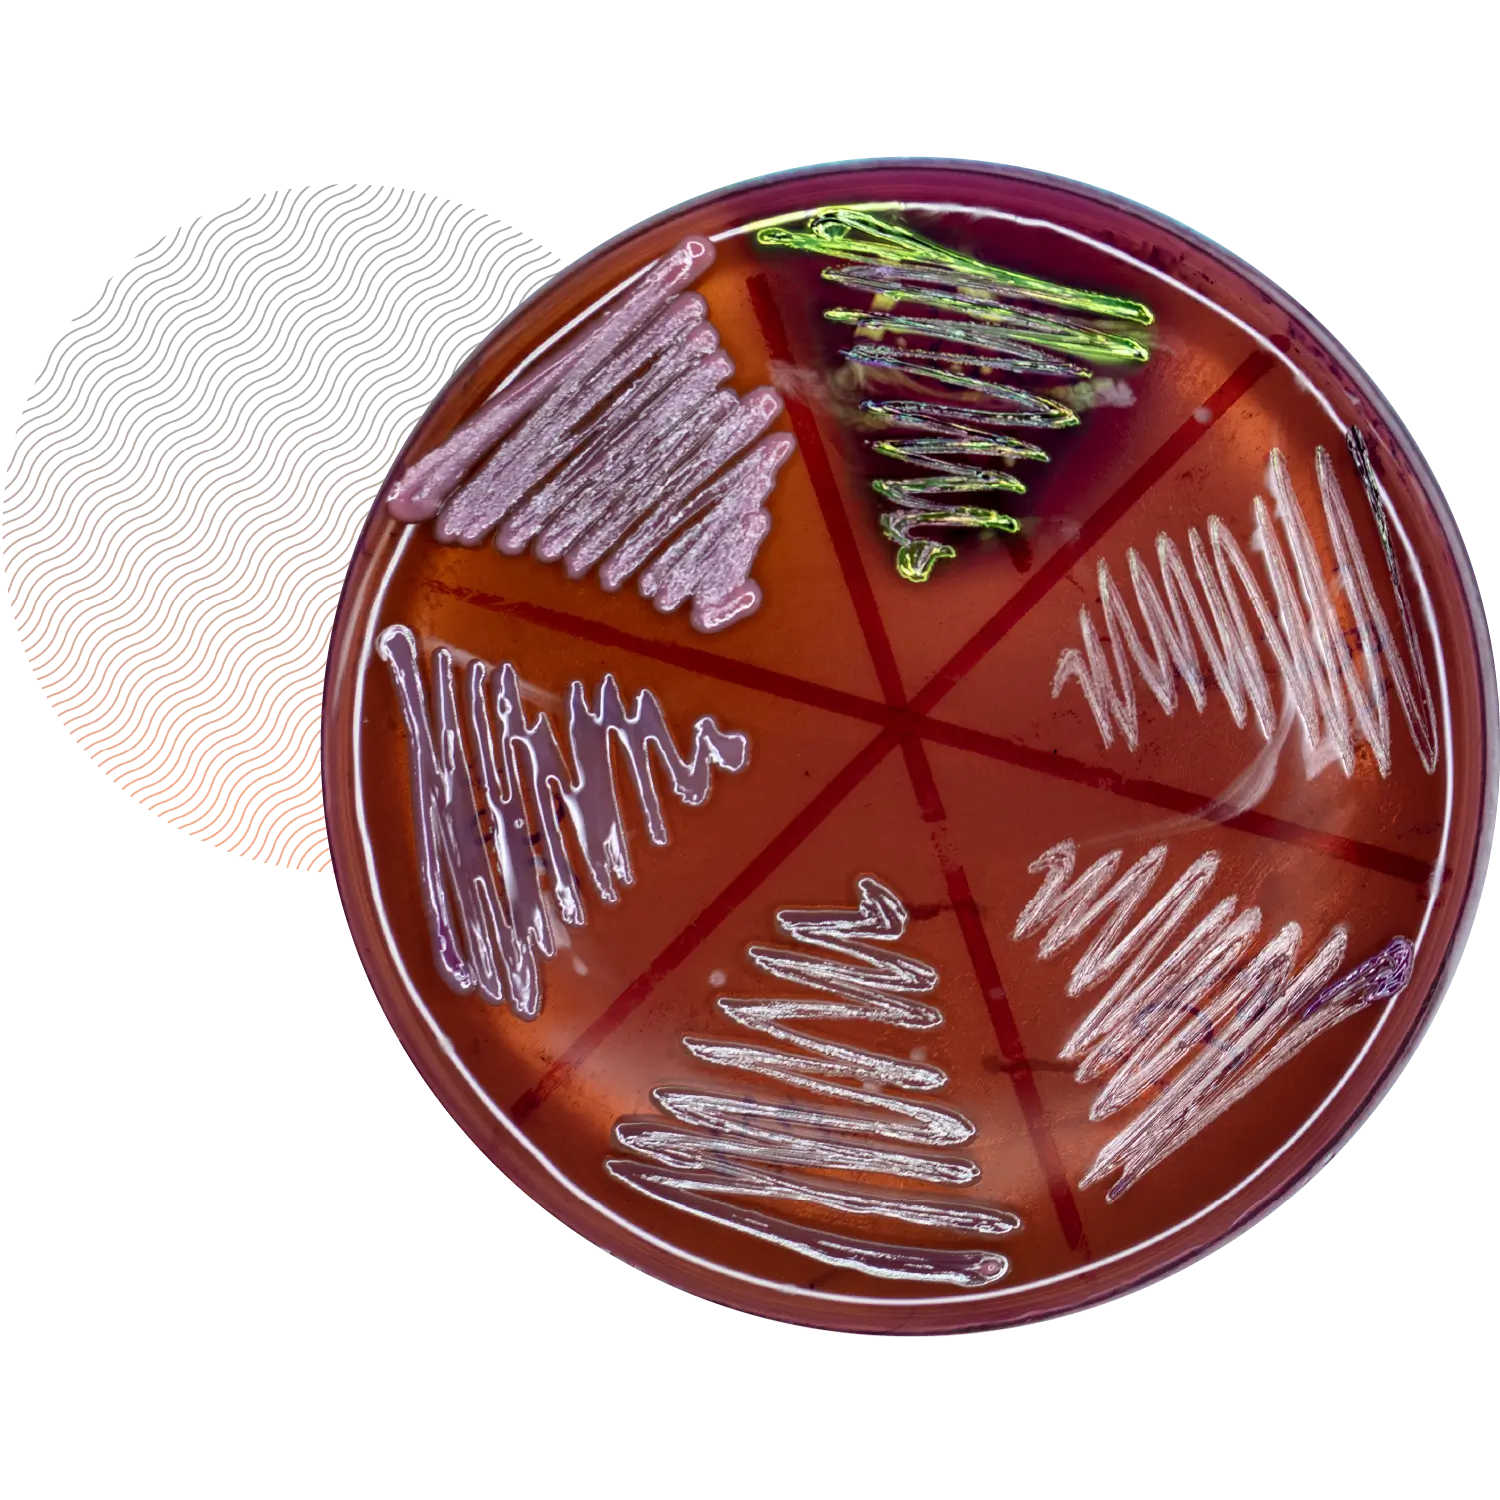

Solutions Hub
Microbial Analysis
Quality Control Testing (QC)
Pathogen Testing
Accredited enumeration, detection and confirmation of foodborne pathogens such as Salmonella, Listeria monocytogenes/Listeria spp., E. coli and Clostridium perfringens. Analyses are designed to meet regulatory, retailer or customer-specific requirements and provide defensible, traceable results for investigations and product release.
Water Testing (including SANS 241)
Environmental Swabbing & Testing (Equipment, Surfaces & Drains)
Planned wet/dry swabs and sponges across food-contact and non-contact surfaces, conveyors and drains; tested for TPC, Enterobacteriaceae, coliforms and Listeria spp. Programs are designed for routine monitoring, hotspot investigation and root-cause analysis to strengthen GMP’s and reduce recall risk.
Hand Swabbing & Testing
Fingertip impressions or hand swabs to quantify the number of colonies and screen for S.aureus/E.coli/coliforms (and specific organisms where required). Use for hygiene audits, training validation and as part of pre-employment or corrective action programs to demonstrate personnel controls.
Environmental Air Testing
Compressed Air Testing
Challenge Testing (Microbial Challenge / Shelf-Life Studies)
Miscellaneous Swabbing & Testing (PPE & Packaging)